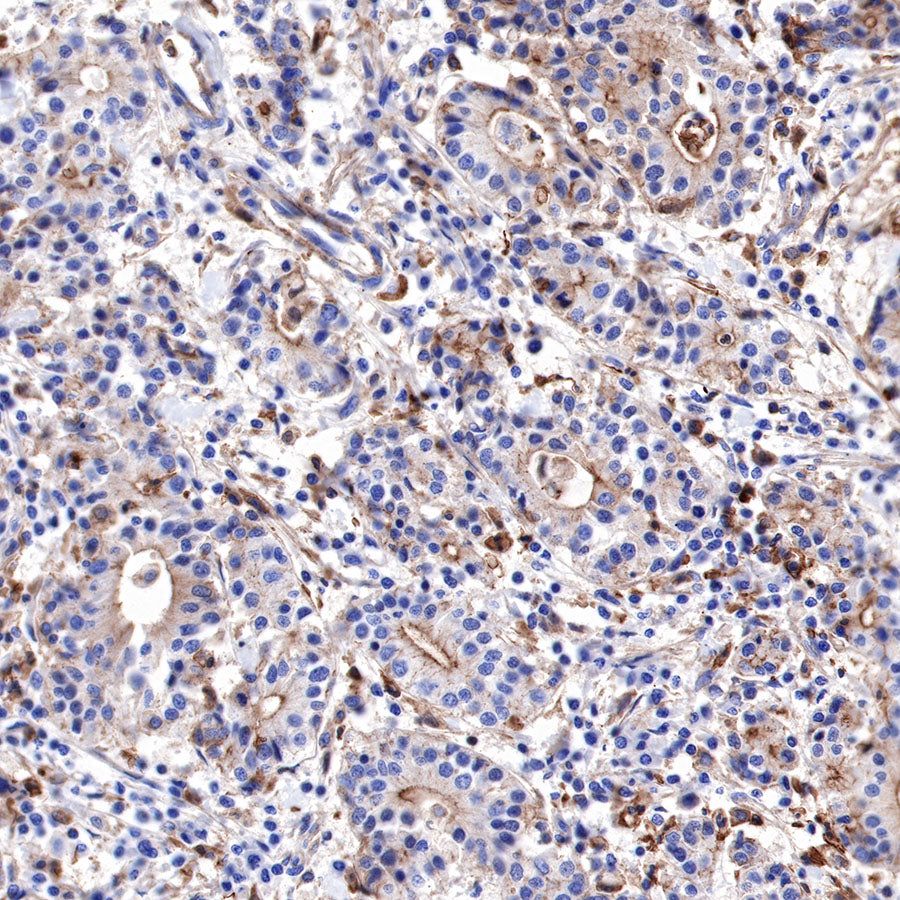

WB result of α-Actinin-1 Rabbit mAb
Primary antibody: α-Actinin-1 Rabbit mAb at 1/1000 dilution
Lane 1: HepG2 whole cell lysate 20 µg
Lane 2: HeLa whole cell lysate 20 µg
Secondary antibody: Goat Anti-Rabbit IgG, (H+L), HRP conjugated at 1/10000 dilution
Predicted MW: 103 kDa
Observed MW: 103 kDa
Product Details
Product Details
Product Specification
Host | Rabbit |
Antigen | α-Actinin-1 |
Synonyms | Alpha-actinin-1, ACTN1 |
Immunogen | Synthetic Peptide |
Location | Cytoplasm, Cytoskeleton, Cell membrane |
Accession | P12814 |
Clone Number | SDT-311-20 |
Antibody Type | Rabbit mAb |
Application | WB, IHC-P |
Reactivity | Hu, Ms, Rt |
Predicted Reactivity | Bv, Mq |
Purification | Protein A |
Concentration | 0.5 mg/ml |
Physical Appearance | Liquid |
Storage Buffer | PBS, 40% Glycerol, 0.05% BSA, 0.03% Proclin 300 |
Stability & Storage | 12 months from date of receipt / reconstitution, -20 °C as supplied. |
Dilution
application | dilution | species |
WB | 1:1000-1:5000 | |
IHC-P | 1:2000 |
Background
Alpha-actinin (α-actinin) is a ubiquitous cytoskeletal protein, which belongs to the superfamily of filamentous actin (F-actin) crosslinking proteins. It is present in multiple subcellular regions of both muscle and non-muscle cells, including cell-cell and cell-matrix contact sites, cellular protrusions and stress fiber dense regions and thus, it seems to bear multiple important roles in the cell by linking the cytoskeleton to many different transmembrane proteins in a variety of junctions. Four isoforms of human α-actinin have already been identified namely, the "muscles" α-actinin-2 and α-actinin-3 and the "non-muscles" α-actinin-1 and α-actinin-4 [PMID: 21241830]. α-actinin-1 is an important intracellular calcium-sensing protein, the major actin crosslinking protein in focal adhesions and stress fibers [PMID: 27272015].
Picture
Picture
Western Blot


WB result of α-Actinin-1 Rabbit mAb
Primary antibody: α-Actinin-1 Rabbit mAb at 1/1000 dilution
Lane 1: mouse liver lysate 20 µg
Lane 2: NIH/3T3 whole cell lysate 20 µg
Secondary antibody: Goat Anti-Rabbit IgG, (H+L), HRP conjugated at 1/10000 dilution
Predicted MW: 103 kDa
Observed MW: 103 kDa

WB result of α-Actinin-1 Rabbit mAb
Primary antibody: α-Actinin-1 Rabbit mAb at 1/1000 dilution
Lane 1: PC-12 whole cell lysate 20 µg
Secondary antibody: Goat Anti-Rabbit IgG, (H+L), HRP conjugated at 1/10000 dilution
Predicted MW: 103 kDa
Observed MW: 103 kDa
Immunohistochemistry

IHC shows positive staining in paraffin-embedded human colon. Anti-α-Actinin-1 antibody was used at 1/2000 dilution, followed by a HRP Polymer for Mouse & Rabbit IgG (ready to use). Counterstained with hematoxylin. Heat mediated antigen retrieval with Tris/EDTA buffer pH9.0 was performed before commencing with IHC staining protocol.

IHC shows positive staining in paraffin-embedded human colon cancer. Anti-α-Actinin-1 antibody was used at 1/2000 dilution, followed by a HRP Polymer for Mouse & Rabbit IgG (ready to use). Counterstained with hematoxylin. Heat mediated antigen retrieval with Tris/EDTA buffer pH9.0 was performed before commencing with IHC staining protocol.

IHC shows positive staining in paraffin-embedded human pancreatic cancer. Anti-α-Actinin-1 antibody was used at 1/2000 dilution, followed by a HRP Polymer for Mouse & Rabbit IgG (ready to use). Counterstained with hematoxylin. Heat mediated antigen retrieval with Tris/EDTA buffer pH9.0 was performed before commencing with IHC staining protocol.

IHC shows positive staining in paraffin-embedded human breast cancer. Anti-α-Actinin-1 antibody was used at 1/2000 dilution, followed by a HRP Polymer for Mouse & Rabbit IgG (ready to use). Counterstained with hematoxylin. Heat mediated antigen retrieval with Tris/EDTA buffer pH9.0 was performed before commencing with IHC staining protocol.

IHC shows positive staining in paraffin-embedded mouse kidney. Anti-α-Actinin-1 antibody was used at 1/2000 dilution, followed by a HRP Polymer for Mouse & Rabbit IgG (ready to use). Counterstained with hematoxylin. Heat mediated antigen retrieval with Tris/EDTA buffer pH9.0 was performed before commencing with IHC staining protocol.

IHC shows positive staining in paraffin-embedded mouse liver. Anti-α-Actinin-1 antibody was used at 1/2000 dilution, followed by a HRP Polymer for Mouse & Rabbit IgG (ready to use). Counterstained with hematoxylin. Heat mediated antigen retrieval with Tris/EDTA buffer pH9.0 was performed before commencing with IHC staining protocol.

IHC shows positive staining in paraffin-embedded rat kidney. Anti-α-Actinin-1 antibody was used at 1/2000 dilution, followed by a HRP Polymer for Mouse & Rabbit IgG (ready to use). Counterstained with hematoxylin. Heat mediated antigen retrieval with Tris/EDTA buffer pH9.0 was performed before commencing with IHC staining protocol.